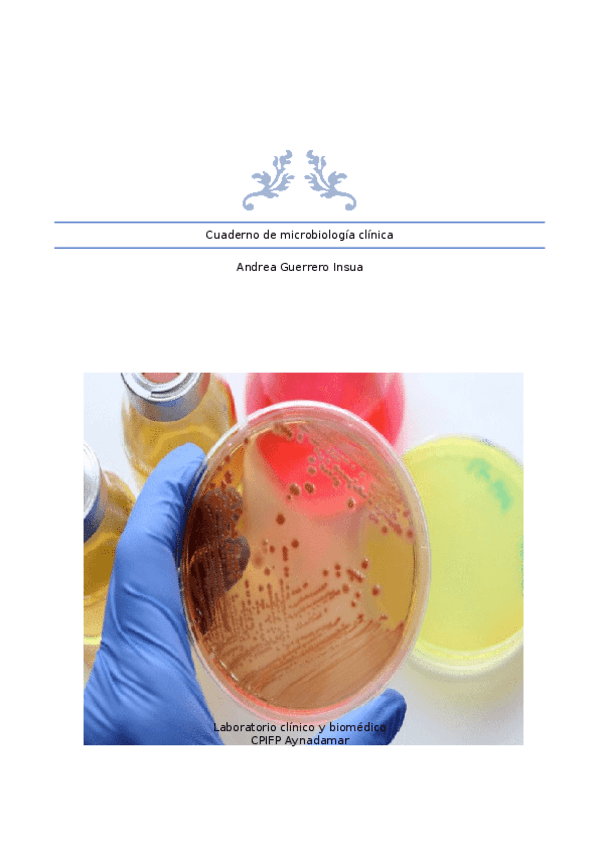

@Andreucha
16 Publicaciones
0 Interacciones
1 Seguidores
1 Siguiendo
Lista de publicaciones de Andreucha
He publicado nuevos apuntes de Empresa e Iniciativa Emprendedora: Proyecto-de-empresa.docx
He publicado nuevos apuntes de Técnicas de análisis hematológico: Cuaderno-Hematologia-todo-el-curso.docx
He publicado nuevos apuntes de Técnicas de inmunodiagnóstico: Cuaderno-Inmuno-1o-trimestre.docx
He publicado nuevos apuntes de Análisis Bioquímico: C.-Bioquimica-Todo-el-curso.docx
He publicado nuevos apuntes de Microbiología Clínica: C.-Microbiologia-2o-trimestre.docx
He publicado nuevos apuntes de Microbiología Clínica: C.-Microbiologia-1o-trimestre.docx